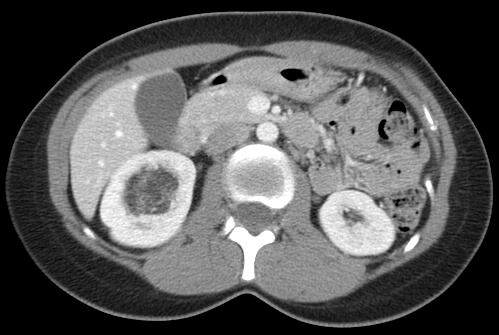
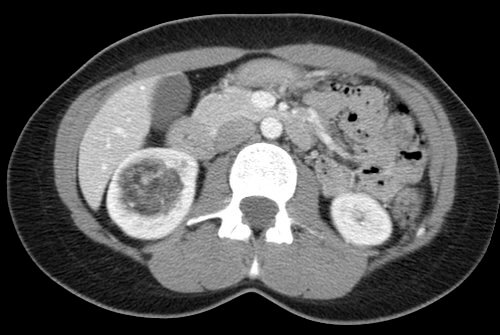
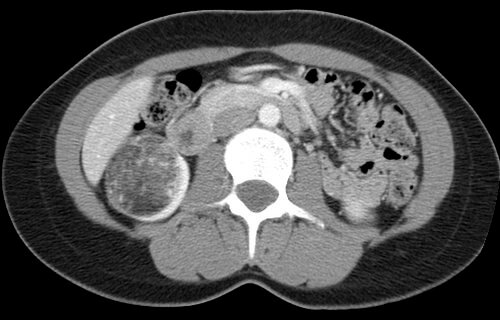

32 year old female who presents with an incidentally discovered right renal angiomyolipoma and undergoes prophylactic embolization.
Comment: This case demonstrates the classic appearance of an angiomyolipoma on CT and the hypervascularity associated with this benign tumor. The clearly seen abnormal vasculature enabled selective catheterization of the dominant supply to the angiomyolipoma and subsequent selective embolization with PVA particles. Embolization can be performed successfully with several types of particulate and/or liquid embolic agents. In this case, PVA was used successfully and no growth or viability has been seen on follow-up imaging after this procedure.